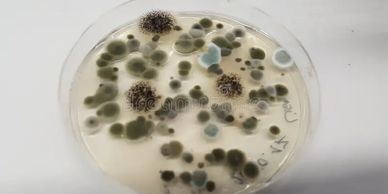
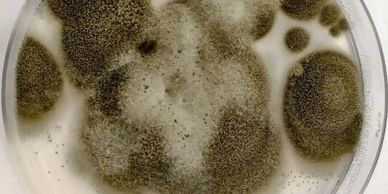
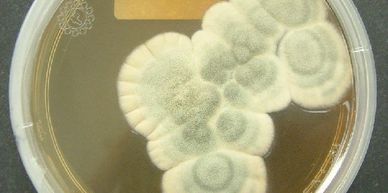
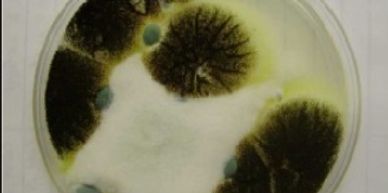
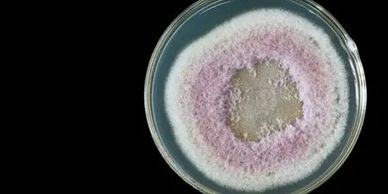

This is one of the most common indoor molds, and can appear in various colors (black, white, yellow, reddish). It thrives in damp, dark places, and can cause respiratory problems and allergies. Some species can become toxigenic.
Often appearing as dark green to black, powdery spots, Cladosporium is frequently found on porous surfaces like carpet, upholstery, wood and paper. It's a common outdoor mold that can easily enter homes through HVAC systems or open windows and can trigger allergies and respiratory issues. Such as sneezing, coughing and itchy eyes.
This mold is recognizable by its blue or green color and velvety texture. it grows quickly on food, walls, and carpets and can cause allergies and respiratory problems.

Typically, grey or black, Alternaria is a common outdoor mold that readily establishes itself indoors, especially in areas with high humidity or water damage. It can grow on wallpaper, textiles, window frames and HVAC systems, and is a significant allergen.
While less common than the others, black mold is highly concerning due to its potential to produce mycotoxins. Its typically dark greenish-black and slimy, growing on materials with prolonged water damage, such as drywall, ceiling tiles, and wood framing. Exposure can lead to severe health issues, including chronic respiratory problems and neurological symptoms.
This mold can range in mold color from black to cream or pink. it's a common indoor mold found in high moisture areas like bathrooms and kitchens, often on tile grout, window frames, caulking, and even indoor air conditioning units. It can cause allergic reactions, including itchy eyes, coughing, and sneezing.
At Air Matters, we understand the importance of having a comfortable and functional home. We offer live culture testing. We have created our own petri dishes for testing. The samples are then incubated in the petri dishes for 3 to 7 days. We can then identify species and spore count, showing our customers the process and what's actually growing in their home, and providing lab results along with pictures.
As a professional mold company, we follow proven remediation procedures to address contamination at the source. We are dedicated to delivering high-quality home services to our customers. We provide a free on-site assessment, including a visual mold inspection, and go over what can be seen. Mold thrives in dark, hard-to-see places, so finding and fixing the moisture issue is the first step. We then set up containment to prevent cross-contamination, which includes using negative air machines, before removing all contaminated materials. An air quality test is provided to ensure materials can be replaced to like-new condition.
We use cookies to analyze website traffic and optimize your website experience. By accepting our use of cookies, your data will be aggregated with all other user data.